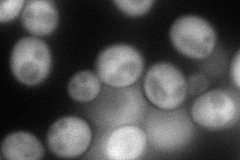
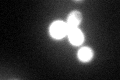

View description
Dimeric hypoxanthine-guanine phosphoribosyltransferase, catalyzes the formation of both inosine monophosphate and guanosine monophosphate; mutations in the human homolog HPRT1 can cause Lesch-Nyhan syndrome and Kelley-Seegmiller syndrome
Localization:
Intensity:
Fold change:
Significance:
-
C’ GFP library in SD

cytosol227.15 -
N' NOP1pr-GFP in SD
cytosol140.994 -
N' TEF2pr-mCherry in SD

cytosol0 -
N' NATIVEpr-GFP in SD

missing0 -
N' TEF2pr-VC and Cyto-VN in SD

missing0 -
C’ GFP library in SD+DTT
cytosol116.210.51Yes -
C’ GFP library in SD+H2O2

cytosol172.130.75No -
C’ GFP library in Starvation Media

nucleusN/AN/AYes -
C’ GFP library on the background of Pup2-DaMP

cytosol -
C’ GFP library on the background of CCT mutant

cytosol186.8120.822373No
